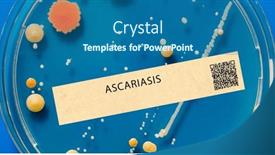
Presentation with cause - Theme having ascariasis-intestinal-parasitic-infection background and a ocean colored foreground
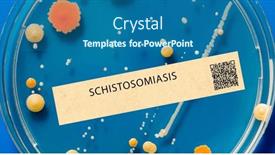
Presentation with cause - Slide set consisting of schistosomiasis-parasitic-infection background and a ocean colored foreground

94 Best Cause-Themed Templates for PowerPoint and Google Slides
CrystalGraphics creates templates designed to make even average presentations look incredible. Below you’ll see thumbnail sized previews of the title slides of a few of our 94 best cause templates for PowerPoint and Google Slides. The text you’ll see in in those slides is just example text. The cause-related image or video you’ll see in the background of each title slide is designed to help you set the stage for your cause-related topics and it is included with that template. In addition to the title slides, each of our templates comes with 17 additional slide layouts that you can use to create an unlimited number of presentation slides with your own added text and images. And every template is available in both widescreen and standard formats. With over 6 million presentation templates available for you to choose from, CrystalGraphics is the award-winning provider of the world’s largest collection of templates for PowerPoint and Google Slides. So, take your time and look around. You’ll like what you see! Whether you want 1 great template or an ongoing subscription, we've got affordable purchasing options and 24/7 download access to fit your needs. Thanks to our unbeatable combination of quality, selection and unique customization options, CrystalGraphics is the company you can count on for your presentation enhancement needs. Just ask any of our thousands of satisfied customers from virtually every leading company around the world. They love our products. We think you will, too!
Features & Pricing
Widescreen (16:9) Presentation Templates. Change size...